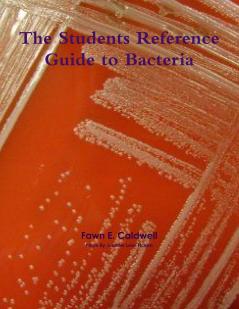
The Students Reference Guide to Bacteria

English
Paperback
₹6906
₹8044
14.15% OFF
(All inclusive*)
Delivery Options
Please enter pincode to check delivery time.
*COD & Shipping Charges may apply on certain items.
Review final details at checkout.
Looking to place a bulk order? SUBMIT DETAILS
About The Book
Description
Author
With this book the student will be able to find the name of the bacteria some of the tests used to identify it and other valuable information. Furthermore there will be some information on what diseases or benefits the bacteria may have. The student will further will be able to learn how to isolate the bacteria to obtain a pure culture and how to identify a Gram Positive (+) or Gram Negative (-) bacterium. A dictionary of Medical and Scientific terminology is also provided. Cover photo by Jennifer Love Icasiano Ficken. Photo credits also for: Dennis Kunkel
Delivery Options
Please enter pincode to check delivery time.
*COD & Shipping Charges may apply on certain items.
Review final details at checkout.
Details
ISBN 13
9781257424160
Publication Date
-06-04-2011
Pages
-116
Weight
-293 grams
Dimensions
-216x280x7.65 mm